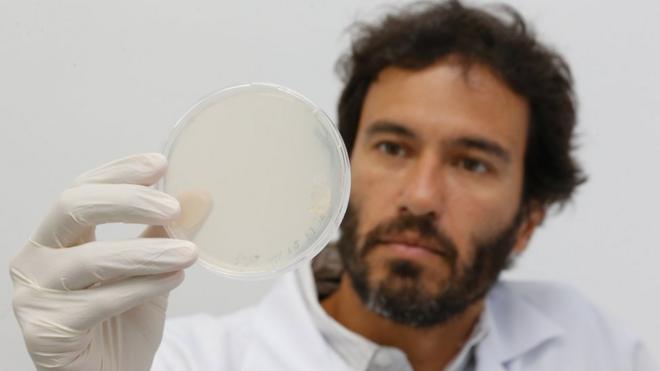
O cientista Júlio César Batista Ferreirajackpot futebol bet365laboratório

A comovente históriajackpot futebol bet365um transplante: 'Éramos duas jovens esperando para ver quem morria primeiro':jackpot futebol bet365
- George Pierpoint
- BBC News

Crédito, Alin Gragossian
Alin Gragossian recebeu um transplantejackpot futebol bet365coraçãojackpot futebol bet365janeirojackpot futebol bet3652019
jackpot futebol bet365 Alin Gragossian,jackpot futebol bet36531 anos, tremia ao abrir a carta da família da mulher cujo coração salvarajackpot futebol bet365vida alguns meses antes.
"Recebi um telefonema do hospital dizendo que a família da minha doadora havia me enviado uma carta. A enfermeira se ofereceu para escanear e me mandar por e-mail imediatamente, mas eu disse a ela que não. Eu simplesmente não estava pronta para ler."
Alguns dias depois, a carta chegou.
Alin conta que caiu aos prantos ao ler sobre a jovem cheiajackpot futebol bet365vida cuja morte salvoujackpot futebol bet365vida.
"É claro que eu sempre soube que minha doadora era um ser humano, mas ler sobre ela como uma pessoa naquele pedaçojackpot futebol bet365papel deixou tudo muito realjackpot futebol bet365repente."
"Ficava arrepiada a cada linha. Tínhamos muitojackpot futebol bet365comum."
"Éramos apenas duas mulheres jovensjackpot futebol bet365diferentes unidadesjackpot futebol bet365terapia intensiva, esperando para ver quem morreria primeiro", refletiu Alin.
Ela publicou um texto sobre a carta nas redes sociais, prometendo fazer "bom uso" do seu novo órgão e "agradecendo do fundo do... nosso coração".
Este item inclui conteúdo extraído do Twitter. Pedimosjackpot futebol bet365autorização antes que algo seja carregado, pois eles podem estar utilizando cookies e outras tecnologias. Você pode consultar a políticajackpot futebol bet365usojackpot futebol bet365cookies e os termosjackpot futebol bet365privacidade do Twitter antesjackpot futebol bet365concordar. Para acessar o conteúdo cliquejackpot futebol bet365"aceitar e continuar".
Finaljackpot futebol bet365Twitter post, 1

Alin, que é da Filadélfia, é uma médica residente que trabalha com medicinajackpot futebol bet365emergência e está se especializandojackpot futebol bet365terapia intensiva.
"Antes disso, eu ligava para a organização responsável pelas doações depois que um paciente morria, como parte do meu trabalho. Agora, eu realmente entendo o poder que esse telefonema pode ter", afirma.

Alin já havia escrito para a famíliajackpot futebol bet365seu doador, mas não tinha como saber se tinham lidojackpot futebol bet365carta.
Nos EUA, as informações sobre um doador só são liberadas para o paciente que recebe o órgão se a família do doador solicitar ou concordar entrarjackpot futebol bet365contato.
O processo variajackpot futebol bet365todo o país, mas os centrosjackpot futebol bet365transplante atuam como intermediários entre as famílias doadoras e os receptores.
A Rede Unida para Compartilhamentojackpot futebol bet365Órgãos (Unos, na siglajackpot futebol bet365inglês), que administra o sistemajackpot futebol bet365doaçãojackpot futebol bet365órgãos nos EUA, incentiva o anonimatojackpot futebol bet365todos os casos.
Como não havia como entrarjackpot futebol bet365contato com eles diretamente, ela decidiu publicar uma resposta endereçada à doadorajackpot futebol bet365seu blog.

Crédito, Alin Gragossian
Alin Gragossian um mês após receber um transplantejackpot futebol bet365coração
"Eu tinha muitas coisasjackpot futebol bet365comum com você. Muito além do nosso tipojackpot futebol bet365sangue", escreveu.
"Nós provavelmente teríamos sido boas amigas. Mas,jackpot futebol bet365vez disso, nossos caminhos se cruzaram da maneira mais estranha. No último dia dajackpot futebol bet365vida, no primeiro dia da minha vida. No pior dia dajackpot futebol bet365vida, no melhor dia da minha vida."
Alin afirma que respeita o desejo da famíliajackpot futebol bet365permanecer anônima, e tem tomado cuidado para não revelar o conteúdo da carta.
No entanto, ela admite esperar que a família da doadora vejajackpot futebol bet365resposta e tenha uma ideia da gratidão que sente.

Crédito, Alin Gragossian
A carta que Alin recebeu da família da doadora
A postagem levou uma sériejackpot futebol bet365pessoas a refletir sobre a conexão entre doadores e receptoresjackpot futebol bet365órgãos.
Alguns pacientes que receberam transplantes disseram que estavam "com um poucojackpot futebol bet365inveja"jackpot futebol bet365Alin por ela ter contato com a famíliajackpot futebol bet365sua doadora.
Este item inclui conteúdo extraído do Twitter. Pedimosjackpot futebol bet365autorização antes que algo seja carregado, pois eles podem estar utilizando cookies e outras tecnologias. Você pode consultar a políticajackpot futebol bet365usojackpot futebol bet365cookies e os termosjackpot futebol bet365privacidade do Twitter antesjackpot futebol bet365concordar. Para acessar o conteúdo cliquejackpot futebol bet365"aceitar e continuar".
Finaljackpot futebol bet365Twitter post, 2

Lynette Hazzard,jackpot futebol bet365Nevada, sabe como é estar do lado da família do doador.
Seu filho, Justen, morreu quando tinha 20 anos.
Ele estava doente há vários anos e conversou com a família sobre o desejojackpot futebol bet365ser doadorjackpot futebol bet365órgãos.
O coração, o pulmão e os rinsjackpot futebol bet365Justen foram doados para quatro pessoas apósjackpot futebol bet365morte.
Lynette escreveu para cada paciente que recebeu um órgão do seu filho.

Crédito, Lynette Hazzard
Justen doou seu coração, pulmão e rins quando morreu aos 20 anos
"Demorei meses para ser capazjackpot futebol bet365escrever uma carta porque não conseguia encontrar as palavras", explicou Lynette. "Era difícil expressar quem nosso filho erajackpot futebol bet365uma pequena carta."
"Eu queria ter certeza que eles soubessem o jovem amoroso, gentil e forte que ele era. Queria ter certeza que eles soubessem que ele gostava tantojackpot futebol bet365ajudar os outros, que escolheu ajudar mesmo depoisjackpot futebol bet365sua morte."
Para Lynette, saber que seu filho ajudou outras pessoas mantémjackpot futebol bet365memória viva.
"Sinto que ele ainda está vivo, vivendo através dos outros. Espero que cada beneficiário dê valor a cada momentojackpot futebol bet365sua vida."

Crédito, Lynette Hazzard
Lynette Hazzard com o filho Justen: 'Sinto que ele ainda está vivo, vivendo através dos outros'

jackpot futebol bet365 Já assistiu aos nossos novos vídeos no YouTube jackpot futebol bet365 ? Inscreva-se no nosso canal!
Este item inclui conteúdo extraído do Google YouTube. Pedimosjackpot futebol bet365autorização antes que algo seja carregado, pois eles podem estar utilizando cookies e outras tecnologias. Você pode consultar a políticajackpot futebol bet365usojackpot futebol bet365cookies e os termosjackpot futebol bet365privacidade do Google YouTube antesjackpot futebol bet365concordar. Para acessar o conteúdo cliquejackpot futebol bet365"aceitar e continuar".
Finaljackpot futebol bet365YouTube post, 1
Este item inclui conteúdo extraído do Google YouTube. Pedimosjackpot futebol bet365autorização antes que algo seja carregado, pois eles podem estar utilizando cookies e outras tecnologias. Você pode consultar a políticajackpot futebol bet365usojackpot futebol bet365cookies e os termosjackpot futebol bet365privacidade do Google YouTube antesjackpot futebol bet365concordar. Para acessar o conteúdo cliquejackpot futebol bet365"aceitar e continuar".
Finaljackpot futebol bet365YouTube post, 2
Este item inclui conteúdo extraído do Google YouTube. Pedimosjackpot futebol bet365autorização antes que algo seja carregado, pois eles podem estar utilizando cookies e outras tecnologias. Você pode consultar a políticajackpot futebol bet365usojackpot futebol bet365cookies e os termosjackpot futebol bet365privacidade do Google YouTube antesjackpot futebol bet365concordar. Para acessar o conteúdo cliquejackpot futebol bet365"aceitar e continuar".
Finaljackpot futebol bet365YouTube post, 3